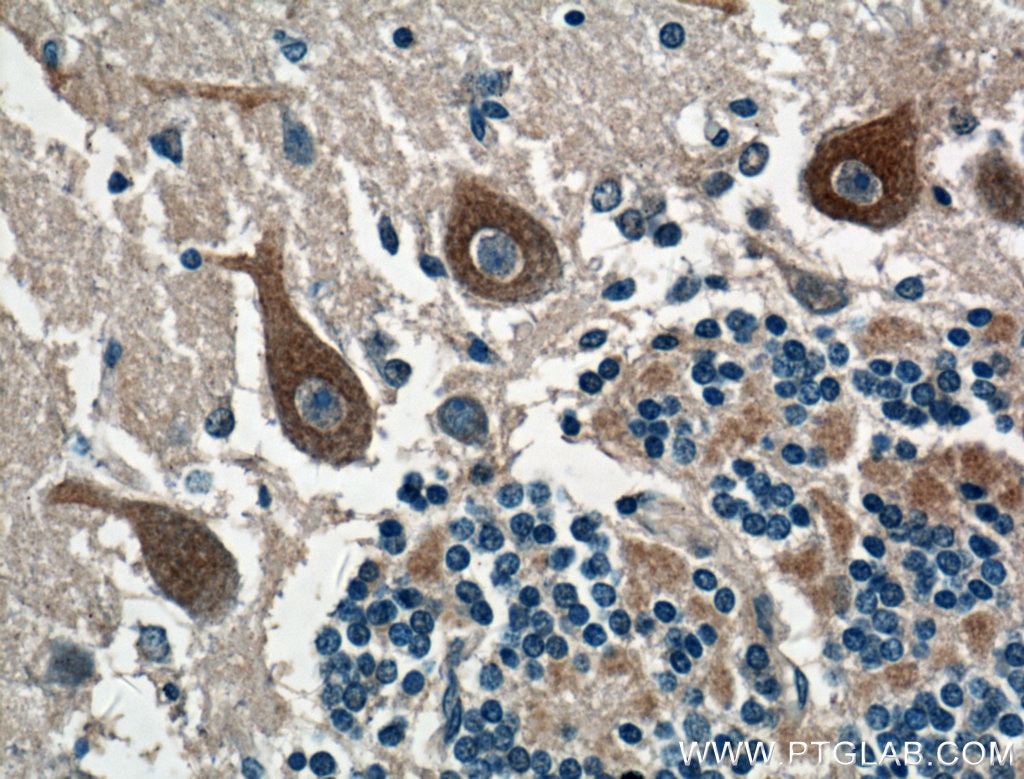

CACNA1G Polyclonal antibody
- Article
- CACNA1G Polyclonal antibody
- Product Number
- 17821-1-AP-150UL
- Supplier
- Proteintech
- Size
- 150 ul
- Description
- The CACNA1G antibody from Proteintech is a rabbit polyclonal antibody to a recombinant protein of human CACNA1G. This antibody recognizes human, mouse, rat antigen. The CACNA1G antibody has been validated for the following applications: IHC, IF-P, ELISA analysis.
- Category
- Antibodies
- Product Group
- Polyclonal Antibodies
- Application
- ELISA, IF, IHC
- Host
- Rabbit
- Species reactivity
- Human, Mouse, Rat
- Conjugate
- Unconjugated
- Formulation
- PBS
- Immunogen
- Fusion Protein
- Synonyms
- Ca(V)T.1; calcium channel, voltage-dependent, T type, alpha 1G subunit; Cav3.1; cav3.1c; NBR13; SCA42; SCA42ND; voltage-dependent calcium channel alpha 1G subunit; voltage-dependent T-type calcium channel alpha 1G subunit; voltage-dependent T-type calcium channel subunit alpha-1G; voltage-gated calcium channel subunit alpha Cav3.1
- Unigene ID
- 8913
- Gene Symbols
- CACNA1G
- Shipping Temperature
- BLUE ICE
- Supplier URL
- Visit supplier product page